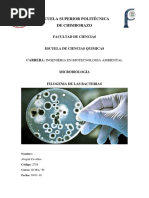

0% encontró este documento útil (0 votos)
132 vistas10 páginasDigestores de Lecho Expandido en Biotecnología
Este documento describe los digestores de lecho expandido. Estos digestores tratan residuos sólidos mediante la expansión del lecho granular para mejorar el contacto entre el efluente y la biomasa. El flujo posee una alta velocidad que mantiene las partículas en constante movimiento y permite la expansión parcial del lecho granular.
Cargado por
Aby CevallosDerechos de autor
© © All Rights Reserved
Nos tomamos en serio los derechos de los contenidos. Si sospechas que se trata de tu contenido, reclámalo aquí.
Formatos disponibles
Descarga como PPTX, PDF, TXT o lee en línea desde Scribd
0% encontró este documento útil (0 votos)
132 vistas10 páginasDigestores de Lecho Expandido en Biotecnología
Este documento describe los digestores de lecho expandido. Estos digestores tratan residuos sólidos mediante la expansión del lecho granular para mejorar el contacto entre el efluente y la biomasa. El flujo posee una alta velocidad que mantiene las partículas en constante movimiento y permite la expansión parcial del lecho granular.
Cargado por
Aby CevallosDerechos de autor
© © All Rights Reserved
Nos tomamos en serio los derechos de los contenidos. Si sospechas que se trata de tu contenido, reclámalo aquí.
Formatos disponibles
Descarga como PPTX, PDF, TXT o lee en línea desde Scribd